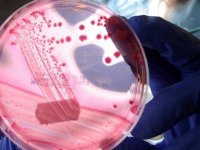
Sağlık Bakanlığı Sma Bilim Kurulundan 'Gen Tedavisi Uygulaması Şu An İçin Uygun Değil' Değerlendirmesi

Sma Haberleri
 DAÜ Eczacılık Fakültesi beyaz önlük giyme töreni düzenleyecekDAÜ Eczacılık Fakültesi beyaz önlük giyme töreni düzenleyecek23 Eylül 2024 Pazartesi 15:08
DAÜ Eczacılık Fakültesi beyaz önlük giyme töreni düzenleyecekDAÜ Eczacılık Fakültesi beyaz önlük giyme töreni düzenleyecek23 Eylül 2024 Pazartesi 15:08 2. Lefkoşa Fotomaraton Fotoğraf Yarışması’nda ödüller verildiLTB ile Yıltan Taşçı Akademi iş birliğindeki yarışmada kazanan ve sergileme alan fotoğraf sahiplerine ödülleri ve belgeleri Merkez Lefkoşa’da düzenlenen törenle takdim edildi04 Ekim 2023 Çarşamba 11:45
2. Lefkoşa Fotomaraton Fotoğraf Yarışması’nda ödüller verildiLTB ile Yıltan Taşçı Akademi iş birliğindeki yarışmada kazanan ve sergileme alan fotoğraf sahiplerine ödülleri ve belgeleri Merkez Lefkoşa’da düzenlenen törenle takdim edildi04 Ekim 2023 Çarşamba 11:45 Osman Kavala'nın tutukluluğunun devamına karar verildi!Birleştirilen Gezi ve Çarşı davasının ikinci duruşmasında Osman Kavala'nın tutukluluk halinin devamına karar verildi.26 Kasım 2021 Cuma 18:02
Osman Kavala'nın tutukluluğunun devamına karar verildi!Birleştirilen Gezi ve Çarşı davasının ikinci duruşmasında Osman Kavala'nın tutukluluk halinin devamına karar verildi.26 Kasım 2021 Cuma 18:02 Osmanlı döneminde yaşanan aşırı hava olayları tarihi belgelerde!TC Cumhurbaşkanlığı Devlet Arşivleri Başkanlığında muhafaza edilen belgelerde, Osmanlı döneminde, aşırı yağış, sel, kuraklık, fırtına gibi afetlerin sıklıkla yaşandığı ve alınan önlemlere ilişkin detaylar yer alıyor.21 Kasım 2021 Pazar 20:13
Osmanlı döneminde yaşanan aşırı hava olayları tarihi belgelerde!TC Cumhurbaşkanlığı Devlet Arşivleri Başkanlığında muhafaza edilen belgelerde, Osmanlı döneminde, aşırı yağış, sel, kuraklık, fırtına gibi afetlerin sıklıkla yaşandığı ve alınan önlemlere ilişkin detaylar yer alıyor.21 Kasım 2021 Pazar 20:13 Avrupa'da 2020'de internette çocuk istismarına ilişkin 1 milyondan fazla şikayet alındıAB Komisyonu üyesi Ylva Johansson, Avrupa'da geçen yıl internet üzerinden çocukların istismar edildiğine dair 1 milyondan fazla şikayet alındığını, bu durumla mücadele için bir merkez kurulmasını önereceğini belirtildi.12 Kasım 2021 Cuma 22:58
Avrupa'da 2020'de internette çocuk istismarına ilişkin 1 milyondan fazla şikayet alındıAB Komisyonu üyesi Ylva Johansson, Avrupa'da geçen yıl internet üzerinden çocukların istismar edildiğine dair 1 milyondan fazla şikayet alındığını, bu durumla mücadele için bir merkez kurulmasını önereceğini belirtildi.12 Kasım 2021 Cuma 22:58 Osmanlı'nın salgın ile mücadelesi: Aşı, karantina ve kapatmaOsmanlı'da ilk aşı uygulamasının 1700'lü yıllarda başladığını ve salgın döneminde kapatma ve karantina gibi tedbirler uygulandı.05 Kasım 2021 Cuma 19:20
Osmanlı'nın salgın ile mücadelesi: Aşı, karantina ve kapatmaOsmanlı'da ilk aşı uygulamasının 1700'lü yıllarda başladığını ve salgın döneminde kapatma ve karantina gibi tedbirler uygulandı.05 Kasım 2021 Cuma 19:20 “Kıbrıs Öykülerini Büyükler Anlatıyor, Gençler Yazıyor” Telsim Kısa Öykü Yarışmasının Ödül Töreni GerçekleştirildiMilli Eğitim ve Kültür Bakanlığı ile Telsim iş birliğinde gerçekleştirilen “Kıbrıs Öykülerini Büyükler Anlatıyor, Gençler Yazıyor” konulu ortaokul ve liselerarası kısa öykü yarışmasında dereceye giren öğrencilere ödülleri törenle verildi.16 Haziran 2021 Çarşamba 17:34
“Kıbrıs Öykülerini Büyükler Anlatıyor, Gençler Yazıyor” Telsim Kısa Öykü Yarışmasının Ödül Töreni GerçekleştirildiMilli Eğitim ve Kültür Bakanlığı ile Telsim iş birliğinde gerçekleştirilen “Kıbrıs Öykülerini Büyükler Anlatıyor, Gençler Yazıyor” konulu ortaokul ve liselerarası kısa öykü yarışmasında dereceye giren öğrencilere ödülleri törenle verildi.16 Haziran 2021 Çarşamba 17:34 Gıda yardımına nasıl başvurulur?K.K.T.C. Çalışma Ve Sosyal Güvenlik Bakanlığı Sosyal Hizmetler Yardım Merkezi Gıda Yardımı Başvuru Formu'na aşağıdaki adrtestenbaşvurabilirsiniz.09 Şubat 2021 Salı 19:24
Gıda yardımına nasıl başvurulur?K.K.T.C. Çalışma Ve Sosyal Güvenlik Bakanlığı Sosyal Hizmetler Yardım Merkezi Gıda Yardımı Başvuru Formu'na aşağıdaki adrtestenbaşvurabilirsiniz.09 Şubat 2021 Salı 19:24 SMA hastalığında gen tedavisine ilişkin yeterli klinik deneme bulunmuyorÖlümcül bir hastalık olan Spinal Musküler Atrofi'de (SMA) gündeme gelen gen tedavisinde kullanılan ilacın etkinliği ve uzun vadeli yan etkileri ile ilişkili yeterli sayıda klinik deneme bulunmadığı belirtildi.07 Ocak 2021 Perşembe 12:53
SMA hastalığında gen tedavisine ilişkin yeterli klinik deneme bulunmuyorÖlümcül bir hastalık olan Spinal Musküler Atrofi'de (SMA) gündeme gelen gen tedavisinde kullanılan ilacın etkinliği ve uzun vadeli yan etkileri ile ilişkili yeterli sayıda klinik deneme bulunmadığı belirtildi.07 Ocak 2021 Perşembe 12:53 Osman ÇOMUNOĞLU'nun Otopsi Sonucu ÇıktıÖlüm sebebi “akrokobik ve hiperofli kalp hastalığı, kalp krizi, kronikleşmiş akciğer hastalığı” sonucu olduğu tespit edildi30 Kasım 2020 Pazartesi 11:52
Osman ÇOMUNOĞLU'nun Otopsi Sonucu ÇıktıÖlüm sebebi “akrokobik ve hiperofli kalp hastalığı, kalp krizi, kronikleşmiş akciğer hastalığı” sonucu olduğu tespit edildi30 Kasım 2020 Pazartesi 11:52 Sağlık Bakanlığı Sma Bilim Kurulundan 'Gen Tedavisi Uygulaması Şu An İçin Uygun Değil' DeğerlendirmesiSMA Bilim Kurulu, SMA hastalarında gen tedavisine ilişkin mevcut verilerin yetersiz olduğu, Kovid-19 sürecinde bağışıklığın baskılanmasının ölüm riskini artırabileceği nedenleriyle gen tedavisi uygulamasının şu an için uygun olmadığını bildirdi.28 Kasım 2020 Cumartesi 14:35
Sağlık Bakanlığı Sma Bilim Kurulundan 'Gen Tedavisi Uygulaması Şu An İçin Uygun Değil' DeğerlendirmesiSMA Bilim Kurulu, SMA hastalarında gen tedavisine ilişkin mevcut verilerin yetersiz olduğu, Kovid-19 sürecinde bağışıklığın baskılanmasının ölüm riskini artırabileceği nedenleriyle gen tedavisi uygulamasının şu an için uygun olmadığını bildirdi.28 Kasım 2020 Cumartesi 14:35 Lapta’da sakin Osman ÇOMUNOĞLU Yaşamını Yitirdi Lapta’da sakin Osman ÇOMUNOĞLU Yaşamını Yitirdi28 Kasım 2020 Cumartesi 10:49
Lapta’da sakin Osman ÇOMUNOĞLU Yaşamını Yitirdi Lapta’da sakin Osman ÇOMUNOĞLU Yaşamını Yitirdi28 Kasım 2020 Cumartesi 10:49 Arter: Maraş’ı Belediye Hudutları İçerisine Birleştirme Noktasına GeliyoruzGazimağusa Belediye Başkanı İsmail Arter Maraş’ta İncelemelerde Bulunup Kapalı Maraş’taki gelişmeler hakkında MHA Ajansına özel röportaj verdi.18 Kasım 2020 Çarşamba 10:15
Arter: Maraş’ı Belediye Hudutları İçerisine Birleştirme Noktasına GeliyoruzGazimağusa Belediye Başkanı İsmail Arter Maraş’ta İncelemelerde Bulunup Kapalı Maraş’taki gelişmeler hakkında MHA Ajansına özel röportaj verdi.18 Kasım 2020 Çarşamba 10:15 KAV, İlkokullar Arası Atık Pil Toplama Yarışması DüzenliyorKanser Araştırma Vakfı (KAV) 1 Kasım 2020 - 1 Şubat 2021 tarihleri arasında İlkokular Arası Atık Pil Toplama Yarışması düzenliyor17 Kasım 2020 Salı 11:03
KAV, İlkokullar Arası Atık Pil Toplama Yarışması DüzenliyorKanser Araştırma Vakfı (KAV) 1 Kasım 2020 - 1 Şubat 2021 tarihleri arasında İlkokular Arası Atık Pil Toplama Yarışması düzenliyor17 Kasım 2020 Salı 11:03 Çalışma Ve Sosyal Güvenlik Bakanlığı: "En ağır cezanın verilmesini sağlayacağız"Çalışma ve Sosyal Güvenlik Bakanlığı, mesai saatleri içerisinde, görevini kötüye kullanarak ahlak ilkeleri ile bağdaşmayan davranışlarda bulunan görevli için, Bakanlık tarafından gerekli yaptırımın ivedilikle uygulanacağını duyurdu.07 Kasım 2020 Cumartesi 10:07
Çalışma Ve Sosyal Güvenlik Bakanlığı: "En ağır cezanın verilmesini sağlayacağız"Çalışma ve Sosyal Güvenlik Bakanlığı, mesai saatleri içerisinde, görevini kötüye kullanarak ahlak ilkeleri ile bağdaşmayan davranışlarda bulunan görevli için, Bakanlık tarafından gerekli yaptırımın ivedilikle uygulanacağını duyurdu.07 Kasım 2020 Cumartesi 10:07 FODER'den Kıbrıs'ın Sokak Oyunlarına Yönelik Fotoğraf YarışmasıBaşvurular 02 Kasım’da Başladı05 Kasım 2020 Perşembe 13:35
FODER'den Kıbrıs'ın Sokak Oyunlarına Yönelik Fotoğraf YarışmasıBaşvurular 02 Kasım’da Başladı05 Kasım 2020 Perşembe 13:35 Çatalköy Belediyesi Kısa Oyun Yazma Yarışması DüzenliyorOyunlar daha önce hiçbir yerde yayınlanmamış , ödül almamış ve oynanmamış olmalıdır. Katılımcıların yarışmaya birden fazla oyunla katılabileceği gibi, grup halinde de oyun yazılabileceği belirtildi.05 Kasım 2020 Perşembe 10:36
Çatalköy Belediyesi Kısa Oyun Yazma Yarışması DüzenliyorOyunlar daha önce hiçbir yerde yayınlanmamış , ödül almamış ve oynanmamış olmalıdır. Katılımcıların yarışmaya birden fazla oyunla katılabileceği gibi, grup halinde de oyun yazılabileceği belirtildi.05 Kasım 2020 Perşembe 10:36 Kıbrıs Türk Halk Masallarını Derleme ve Anlatma Yarışması’nın sonuçları AçıklandıMilli Eğitim ve Kültür Bakanlığı’na bağlı Kültür Dairesi’nin düzenlediği, Kıbrıs Türk Halk Masallarını Derleme ve Anlatma Yarışması’nın sonuçları açıklandı…04 Kasım 2020 Çarşamba 12:29
Kıbrıs Türk Halk Masallarını Derleme ve Anlatma Yarışması’nın sonuçları AçıklandıMilli Eğitim ve Kültür Bakanlığı’na bağlı Kültür Dairesi’nin düzenlediği, Kıbrıs Türk Halk Masallarını Derleme ve Anlatma Yarışması’nın sonuçları açıklandı…04 Kasım 2020 Çarşamba 12:29 İskele Belediyesi İskele Ve Köylerinde Kış Hazırlıklarını SürdürüyorYağmur suyu drenaj hattı çalışmaları devam ediyor. Bozuk yollarda bakım onarım çalışması yapılıyor03 Kasım 2020 Salı 13:21
İskele Belediyesi İskele Ve Köylerinde Kış Hazırlıklarını SürdürüyorYağmur suyu drenaj hattı çalışmaları devam ediyor. Bozuk yollarda bakım onarım çalışması yapılıyor03 Kasım 2020 Salı 13:21 Bakan Karaismailoğlu: Amacımız En Kısa Zamanda Enkaz Altındakilere UlaşmakUlaştırma ve Altyapı Bakanı Adil Karaismailoğlu, enkaz altındakilere ulaşmak için yoğun çaba sarf ettiklerini bildirdi.31 Ekim 2020 Cumartesi 12:25
Bakan Karaismailoğlu: Amacımız En Kısa Zamanda Enkaz Altındakilere UlaşmakUlaştırma ve Altyapı Bakanı Adil Karaismailoğlu, enkaz altındakilere ulaşmak için yoğun çaba sarf ettiklerini bildirdi.31 Ekim 2020 Cumartesi 12:25 YDP: Anket Çalışmalarına Yasal Bir Düzenleme YapılmalıdırKKTC de seçim dönemlerinde manipülatif anketler siyaset üzerinde ciddi etkilere sebebiyet vermektedir.30 Ekim 2020 Cuma 13:02
YDP: Anket Çalışmalarına Yasal Bir Düzenleme YapılmalıdırKKTC de seçim dönemlerinde manipülatif anketler siyaset üzerinde ciddi etkilere sebebiyet vermektedir.30 Ekim 2020 Cuma 13:02 Pandemide Cepten Konuşma RekoruSalgın sürecinde Nisan-Haziran aylarında cepten konuşma rekoru kırıldı. Salgının etkili olduğu aylarda aylık ortalama konuşma 544 dakikaya yükseldi. Türkiye bu süreyle Avrupa'da en çok cepten konuşan ülke oldu.29 Ekim 2020 Perşembe 10:13
Pandemide Cepten Konuşma RekoruSalgın sürecinde Nisan-Haziran aylarında cepten konuşma rekoru kırıldı. Salgının etkili olduğu aylarda aylık ortalama konuşma 544 dakikaya yükseldi. Türkiye bu süreyle Avrupa'da en çok cepten konuşan ülke oldu.29 Ekim 2020 Perşembe 10:13 Ombudsman Dizdarlı, Su Borcuyla İlgili Bir Başvuru Üzerine Hazırlanan Raporu AçıkladıYüksek Yönetim Denetçisi (Ombudsman) Emine Dizdarlı, Alican Özenci’nin su borcuyla ilgili başvurusu üzerine hazırlanan raporu açıkladı21 Ekim 2020 Çarşamba 12:47
Ombudsman Dizdarlı, Su Borcuyla İlgili Bir Başvuru Üzerine Hazırlanan Raporu AçıkladıYüksek Yönetim Denetçisi (Ombudsman) Emine Dizdarlı, Alican Özenci’nin su borcuyla ilgili başvurusu üzerine hazırlanan raporu açıkladı21 Ekim 2020 Çarşamba 12:47 Katliam şebekesi saat 01.00'de vurdu! Dehşetin boyutu gün ağarınca ortaya çıktıGelen son dakika haberine göre, Ermenistan ikinci kez Azerbaycan'ın Gence kentindeki sivilleri orta menzilli balistik füzeyle uykudayken vurdu.17 Ekim 2020 Cumartesi 09:02
Katliam şebekesi saat 01.00'de vurdu! Dehşetin boyutu gün ağarınca ortaya çıktıGelen son dakika haberine göre, Ermenistan ikinci kez Azerbaycan'ın Gence kentindeki sivilleri orta menzilli balistik füzeyle uykudayken vurdu.17 Ekim 2020 Cumartesi 09:02 Çarpışmaya saatler kaldı! Uzay çöplüğü miktarı yüzde 20 artabilir!Rus uydusu ile Çin roketi çarpışabilir! Saatler sonra gerçekleşmesi beklenen çarpışma, uzay çöplüğü miktarını yüzde 20 arttırabilir!16 Ekim 2020 Cuma 14:30
Çarpışmaya saatler kaldı! Uzay çöplüğü miktarı yüzde 20 artabilir!Rus uydusu ile Çin roketi çarpışabilir! Saatler sonra gerçekleşmesi beklenen çarpışma, uzay çöplüğü miktarını yüzde 20 arttırabilir!16 Ekim 2020 Cuma 14:30 Meksika'da Polisle Çatışan 6 Çete Üyesi ÖldürüldüÜlkede şiddet olaylarının en yoğun olduğu eyaletlerden Guanajuato'da ay başından bu yana 103 kişi hayatını kaybetti. 16 Ekim 2020 Cuma 09:44
Meksika'da Polisle Çatışan 6 Çete Üyesi ÖldürüldüÜlkede şiddet olaylarının en yoğun olduğu eyaletlerden Guanajuato'da ay başından bu yana 103 kişi hayatını kaybetti. 16 Ekim 2020 Cuma 09:44 Türk Birliği Dayanışma Derneği Öğrencilere 30 Tablet DağıttıTürk Birliği Dayanışma Derneği Yönetim Kurulu üyeleri Doç.Dr Melahat Arıklı ve Olcay Kara, sosyal sorumluluk çalışmaları çerçevesinde öğrencilere 30 tablet dağıttı.13 Ekim 2020 Salı 12:30
Türk Birliği Dayanışma Derneği Öğrencilere 30 Tablet DağıttıTürk Birliği Dayanışma Derneği Yönetim Kurulu üyeleri Doç.Dr Melahat Arıklı ve Olcay Kara, sosyal sorumluluk çalışmaları çerçevesinde öğrencilere 30 tablet dağıttı.13 Ekim 2020 Salı 12:30 Ermenistan-Azerbaycan cephe hattında son durumAzerbaycan, Karabağ’da ilerleyişini sürdürüyor. Ermenistan ordusu ise birçok noktada tank ve mühimmatlarını bırakarak mevzilerden kaçıyor, kalmaya çalıştığı cephelerde ise tankları gizlemeye çalışıyor.09 Ekim 2020 Cuma 09:11
Ermenistan-Azerbaycan cephe hattında son durumAzerbaycan, Karabağ’da ilerleyişini sürdürüyor. Ermenistan ordusu ise birçok noktada tank ve mühimmatlarını bırakarak mevzilerden kaçıyor, kalmaya çalıştığı cephelerde ise tankları gizlemeye çalışıyor.09 Ekim 2020 Cuma 09:11 Ombudsman’a 6 Ayda 38 BaşvuruDizdarlı, raporunda, dairede alınan önlemler hakkında detaylara yer verdi.08 Ekim 2020 Perşembe 11:10
Ombudsman’a 6 Ayda 38 BaşvuruDizdarlı, raporunda, dairede alınan önlemler hakkında detaylara yer verdi.08 Ekim 2020 Perşembe 11:10- 22:02 - Basketbolda Kılıf &Kılıf Prolig heyecanı başlıyor...
- 20:23 - Valizinden 32 kilo kuyruk yağı, 3 kilo biber çıktı!
- 20:00 - Ülke genelindeki trafik denetimlerinde 321 sürücü rapor edildi
- 19:58 - Yarın şiddetli yağış bekleniyor
- 18:54 - ARUCAD’da Empati Atölyesi Gerçekleştirildi
- 18:53 - Sanat, Hafıza ve Gelecek Aynı Sergide
- 17:52 - Uyuşturucu soruşturmasında ünlü isimler için serbest bırakma kararı
- 17:49 - Gazimağusa’da sahte resmi evrakla hisse devri: 1 kişi tutuklandı!
- 17:48 - 10 günlük bütçe maratonu bugün tamamlanıyor
- 17:47 - Lefkoşa-Girne ana yolunda ulaşım bir ay boyunca geliş güzergahından sağlanacak
- 17:46 - Alayköy-Metehan Çevre Yolu’nun bir bölümü yarın bisiklet yarışı nedeniyle trafiğe kapatılacak
- 17:45 - Girne - Tatlısu Anayolunda kaza!
- 14:00 - Kıbrıslı Rum ressam Yorgos Gavriil’in evine patlayıcı madde ile saldırıldı!
- 13:59 - LTB, şap hastalığına karşı tedbirleri arttırarak sürdürüyor
- 13:58 - Lefke Sivil Toplum Örgütleri Platformu: Lefke Gazi Lisesi mevcut yerinde kalmalı
 Kilo Verdiren Besinler
Kilo Verdiren Besinler Birlikte Büyüyen Hayvanların Öncesi ve Sonrası
Birlikte Büyüyen Hayvanların Öncesi ve Sonrası Duygusal Zekâsı Yüksek ve Hisleri Kuvvetli İnsanlarda Görülen 11 Özellik
Duygusal Zekâsı Yüksek ve Hisleri Kuvvetli İnsanlarda Görülen 11 Özellik Atatürk’ün az bilinen fotoğrafları
Atatürk’ün az bilinen fotoğrafları
12345678
Tüm Hakları Saklıdır © 2014 Detay Kıbrıs | İzinsiz ve kaynak gösterilmeden yayınlanamaz.
Tel : +90 392 444 79 79 - +90 533 851 38 51 Faks : [email protected]
Tel : +90 392 444 79 79 - +90 533 851 38 51 Faks : [email protected]











































